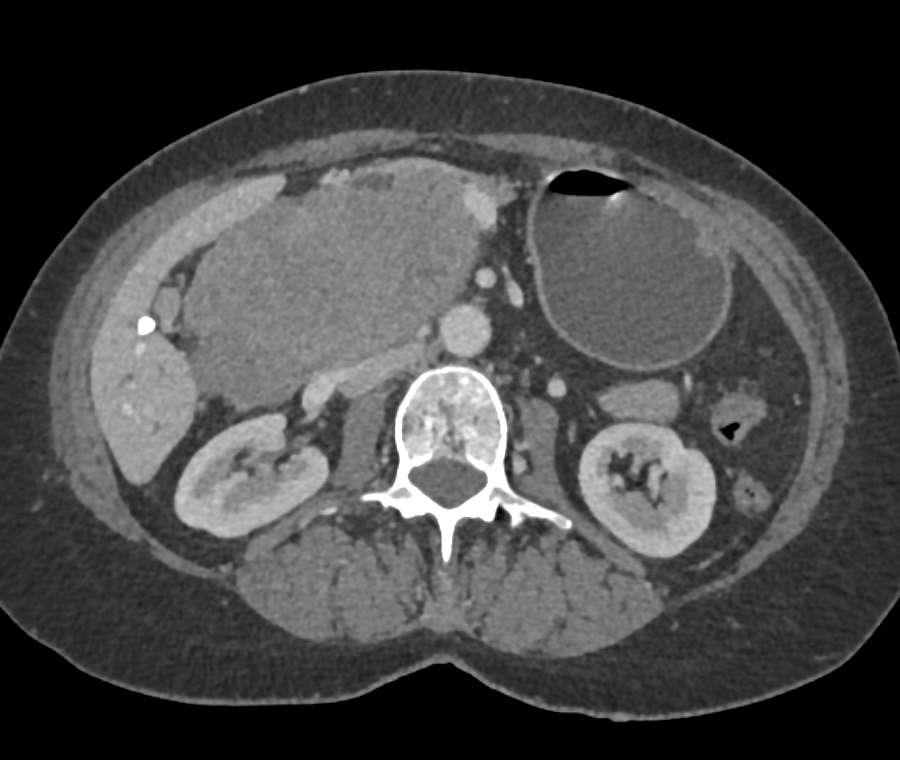

Diagnostic Case Quiz ❯ Quiz of the Month ❯ November 2024
Archives:
Instructions
- Login / Register to CTisus.com to save your answers and track your score and progress.
- Review your answers below.
- Click on thumbnail images to view a larger version of the image
- Select the best answer
- Submit your answers by selecting the "Submit" button at the end of the quiz.
Quiz Discussion
1) The most likely dx in this 50ish yr old male is?


SPEN tumor
serous cystadenoma
pancreatic adenocarcinoma
neuroendocrine tumor (PNET)
2) The least likely dx in this case is?


neuroendocrine tumor
ectopic pancreatic rest
glomus tumor
gastric polyp
3) The most likely diagnosis in this patient is?


gastric adenocarcinoma
familial polyposis
fundic gland polyps
GIST tumors
4) The most likely diagnosis in this case is?


adrenal metastases
adrenal lymphoma
adrenal adenoma
adrenal pheochromocytoma
5) In this hypertensive patient the best diagnosis is?


bladder cancer
pheochromocytoma
bladder polyp
multifocal TCC
6) In this patient with abdominal pain the best dx is?


treated lymphoma
sclerosing mesenteritis
carcinoid tumor
TB
7) The least likely dx in this case sent to PMDC is?

pancreatic adenocarcinoma
metastatic melanoma
gastric GIST tumor
primary duodenal carcinoma
9) The most likely diagnosis in this case is?


lymphoma
adenocarcinoma
carcinoid tumor
Meckel’s diverticulum